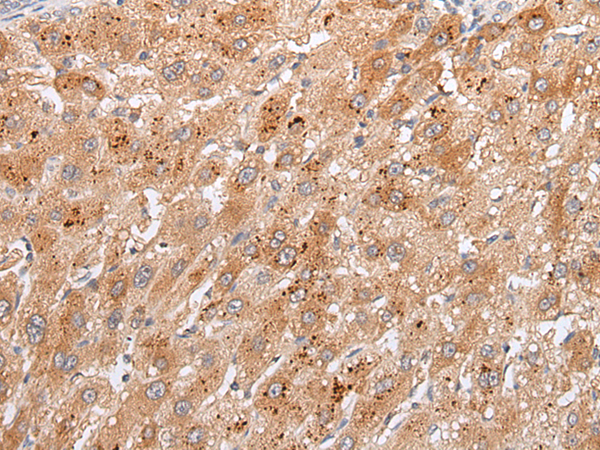
一抗

|
Background: |
Cell surface heparan sulfate proteoglycans are composed of a membrane-associated protein core substituted with a variable number of heparan sulfate chains. Members of the glypican-related integral membrane proteoglycan family (GRIPS) contain a core protein anchored to the cytoplasmic membrane via a glycosyl phosphatidylinositol linkage. These proteins may play a role in the control of cell division and growth regulation. The GPC4 gene is adjacent to the 3' end of GPC3 and may also play a role in Simpson-Golabi-Behmel syndrome. |
|
Applications: |
ELISA, WB, IHC |
|
Name of antibody: |
GPC4 |
|
Immunogen: |
Synthetic peptide of human GPC4 |
|
Full name: |
glypican 4 |
|
Synonyms: |
K-glypican |
|
SwissProt: |
O75487 |
|
ELISA Recommended dilution: |
5000-10000 |
|
IHC positive control: |
Human liver cancer |
|
IHC Recommend dilution: |
25-100 |
|
WB Predicted band size: |
62 kDa |
|
WB Positive control: |
Human pancreas tissue |
|
WB Recommended dilution: |
500-2000 |


 購物車
購物車 幫助
幫助
 021-54845833/15800441009
021-54845833/15800441009